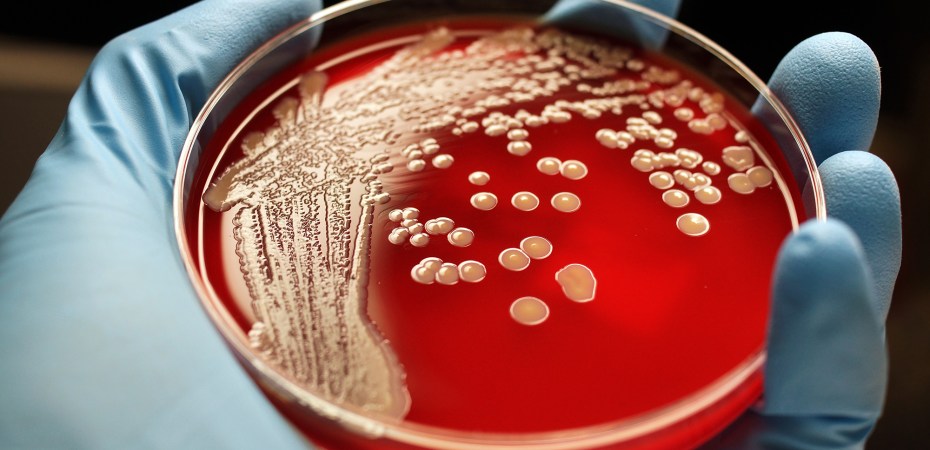

The Columbus County Health Department said Friday that they are preparing to test over “200 students” after a confirmed Tuberculosis exposure at East Columbus Jr./Sr. High School.
Columbus County Schools Communications Director Kelly Jones confirmed these reports to NHPCM Friday, and said the county health department will begin testing January 21st. The health department told local outlet WWAY TV3 that they are awaiting the test to be delivered.
This is a developing story.